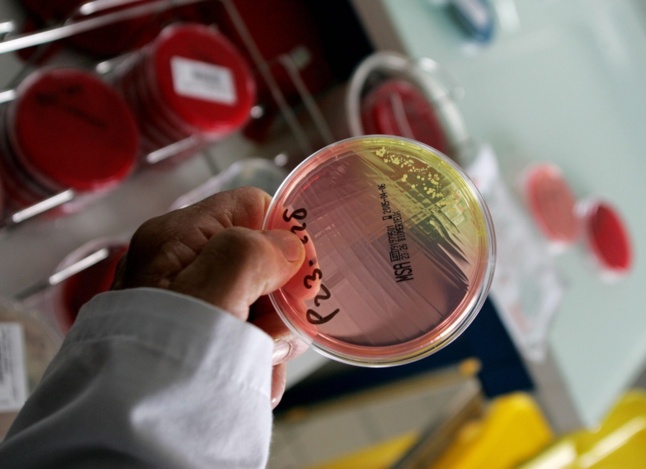

Ce n'est pas la première fois qu'on entend ce genre d'annonce. Différentes équipes à travers le monde s'intéressent à cette problématique, avec des approches curatives très différentes. Les progrès effectués en 30 ans sont spectaculaires, particulièrement sur les traitements et les trithérapies aujourd'hui capables de maitriser l'infection au VIH. Un séropositif traité a presque la même espérance de vie qu'une personne séronégative. Cependant, malgré de nombreuses tentatives, on ne guérit toujours pas d'une infection au VIH.
L'approche de l'équipe danoise consiste à attaquer le VIH dans les réservoirs viraux. Les réservoirs du VIH correspondent à certains compartiments anatomiques et cellulaires où le virus rentre dès les premières semaines de l'infection et où il est impossible pour les trithérapies actuelles de le déloger. Ces réservoirs produisent par la suite de nouvelles copies du virus qui rendent l'infection permanente.
Grâce à une nouvelle molécule, que l'équipe danoise est en train de tester, ce traitement serait donc capable d'entrer dans ces réservoirs et d'expulser le VIH de l'ADN. Cette activation des réservoirs permettrait ensuite au système immunitaire, aidé par d'autres traitements, de supprimer définitivement le virus du corps humain. Les tests en laboratoire se sont révélés très prometteurs, ce qui a permis à cette équipe de chercheurs d'obtenir un financement public de 12 millions de couronnes danoises (1,6 million d'euros) du Conseil danois de recherche, dépendant du ministère des Sciences.
Les chercheurs passent maintenant aux essais cliniques sur 15 patients séropositifs. Les premiers résultats sont attendus pour la fin de l'année 2013. L'équipe espère ainsi que ces essais permettront de prouver qu'il est possible d'activer les réservoirs du VIH et de traiter définitivement les personnes séropositives.
Aujourd’hui, la seule personne guérie définitivement du VIH est le « patient de Berlin ». Séropositif et atteint d'une leucémie, ce patient, après avoir reçu un greffe de moelle osseuse, a été guéri. La moelle osseuse provenait de donneurs possédant une mutation cellulaire rendant impossible chez ces personnes l'infection au VIH. Cette mutation est présente dans 0,3 % de la population mondiale. La greffe a donc permis de « transmettre » cette mutation au patient et son système immunitaire a ainsi pu éliminer définitivement le virus qui ne pouvait plus pénétrer dans de nouvelles cellules. Cependant, une greffe de moelle osseuse n'est pas envisageable à grande échelle pour le traitement d'une infection VIH. L'opération est extrêmement risquée et les donneurs sont rares.
Cette recherche ouvre donc un nouvel espoir dans la lutte contre le VIH. Il faut cependant se méfier de l'effet d'annonce, car ce n'est pas la première fois que des chercheurs essaient de s'attaquer aux réservoirs viraux du VIH et à chaque fois ces tentatives ont échoué. L'équipe danoise sera-t-elle capable de prouver le contraire ?
L'approche de l'équipe danoise consiste à attaquer le VIH dans les réservoirs viraux. Les réservoirs du VIH correspondent à certains compartiments anatomiques et cellulaires où le virus rentre dès les premières semaines de l'infection et où il est impossible pour les trithérapies actuelles de le déloger. Ces réservoirs produisent par la suite de nouvelles copies du virus qui rendent l'infection permanente.
Grâce à une nouvelle molécule, que l'équipe danoise est en train de tester, ce traitement serait donc capable d'entrer dans ces réservoirs et d'expulser le VIH de l'ADN. Cette activation des réservoirs permettrait ensuite au système immunitaire, aidé par d'autres traitements, de supprimer définitivement le virus du corps humain. Les tests en laboratoire se sont révélés très prometteurs, ce qui a permis à cette équipe de chercheurs d'obtenir un financement public de 12 millions de couronnes danoises (1,6 million d'euros) du Conseil danois de recherche, dépendant du ministère des Sciences.
Les chercheurs passent maintenant aux essais cliniques sur 15 patients séropositifs. Les premiers résultats sont attendus pour la fin de l'année 2013. L'équipe espère ainsi que ces essais permettront de prouver qu'il est possible d'activer les réservoirs du VIH et de traiter définitivement les personnes séropositives.
Aujourd’hui, la seule personne guérie définitivement du VIH est le « patient de Berlin ». Séropositif et atteint d'une leucémie, ce patient, après avoir reçu un greffe de moelle osseuse, a été guéri. La moelle osseuse provenait de donneurs possédant une mutation cellulaire rendant impossible chez ces personnes l'infection au VIH. Cette mutation est présente dans 0,3 % de la population mondiale. La greffe a donc permis de « transmettre » cette mutation au patient et son système immunitaire a ainsi pu éliminer définitivement le virus qui ne pouvait plus pénétrer dans de nouvelles cellules. Cependant, une greffe de moelle osseuse n'est pas envisageable à grande échelle pour le traitement d'une infection VIH. L'opération est extrêmement risquée et les donneurs sont rares.
Cette recherche ouvre donc un nouvel espoir dans la lutte contre le VIH. Il faut cependant se méfier de l'effet d'annonce, car ce n'est pas la première fois que des chercheurs essaient de s'attaquer aux réservoirs viraux du VIH et à chaque fois ces tentatives ont échoué. L'équipe danoise sera-t-elle capable de prouver le contraire ?